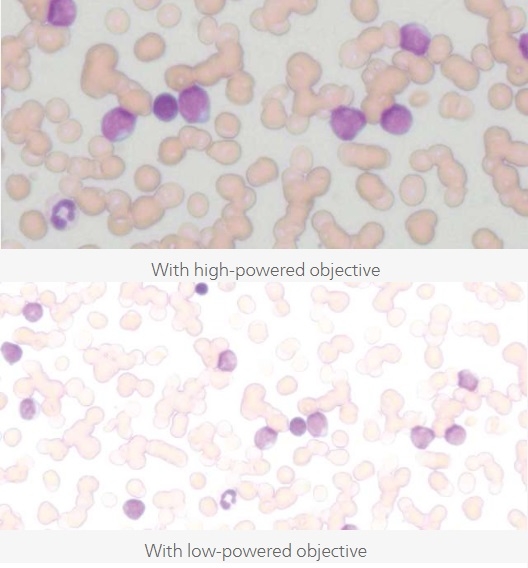

Nikon ECLIPSE Si
The new Nikon ECLIPSE Si Upright Microscope was designed for user, who spend hour using microscope. The ECLIPSE Si is ergonomically designed to enhance operational efficiency. This is the new powerful instrument helps you to stay focused for longer. To help users quickly learn how to operate Si by scanning the QR code beside the microscope.
Observation with FOV of 22 mm
The ECLIPSE Si can enhance the efficiency of clinical observations when equipped with FOV 22 tubes* and lenses that enable a large 22 mm field of view.
Adjusting focus and moving the stage with one hand
The coarse and fine focus knobs are located on both sides of the microscope, making it possible to focus with either hand. In addition, the illumination brightness is shown in a bar graph on the LCD as in front of the microscope.
Block blue component in LED light
The ECLIPSE Si offerd an optional blue light blocking filter that can be placed in the field lens to remove the blue component of the LED light.
Maintaining comfortable brightness when switching magnifications
The ECLIPSE Si features the intelligent Light Intensity Management (LIM) which automatically remembers and sets the light intensity level for each objective. The LIM feature reduces up to 40% of the time spent on adjusting light intensities*.
Observation with FOV of 22 mm
The ECLIPSE Si can enhance the efficiency of clinical observations when equipped with FOV 22 tubes* and lenses that enable a large 22 mm field of view.
Adjusting focus and moving the stage with one hand
The coarse and fine focus knobs are located on both sides of the microscope, making it possible to focus with either hand. In addition, the illumination brightness is shown in a bar graph on the LCD as in front of the microscope.
Block blue component in LED light
The ECLIPSE Si offerd an optional blue light blocking filter that can be placed in the field lens to remove the blue component of the LED light.
Maintaining comfortable brightness when switching magnifications
The ECLIPSE Si features the intelligent Light Intensity Management (LIM) which automatically remembers and sets the light intensity level for each objective. The LIM feature reduces up to 40% of the time spent on adjusting light intensities*.
Related Products
-
 New
NewHT-X1™ mini : Holotomography I…
-
 New
NewFACSCOPE® B
-
 New
NewCelloger®
-
 New
NewMACSima™ Imaging Platform
-
 Hot
HotTomocube HT-X1
-
 New
NewDigitail
-
 New
NewLabstamp
-
 New
NewIntravital Microscopy
-
 Hot
HotCA Series - Multiple Output Em…
-

Confocal and Multiphoton micro…
-
 New
NewNikon Eclipse Ui
-

IM-21 Microinjector
-

IM-11-2 Pneumatic Microinjecto…
-

ONGO SPERM
-

Injection, holding and biopsy …
-

INTEGRAL HSV
-

DIVA
-

SYMS III sealer
-

Digitcool freezers
-
 Hot
HotMN-2 Mini Bench Top Incubator
-

EMBRYO SHIELD – INLINE FILTER
-

MV60 Wireless Multi-viewing, W…
-
Biopsy micropipettes
-
ICSI Micropipettes
-
Holding Micropipettes
-
DENU-Tips
-
 New
NewDigital Sight Cameras for Micr…
-

Nikon ECLIPSE Ci-L Plus, Uprig…
-
 Hot
HotiXon Ultra 897 facilitates a n…
-
 Hot
HotZL41 Cell sCMOS camera offer a…
-

The Observer XT : Professional…
-

by PET, SPECT, Optical Imaging…
-
 New
NewUltraMicroscope Blaze: The aut…
-
 Hot
HotDigital Classroom
-

EthoVision XT: Animal Behavior…
-

Digital Sight Cameras for Micr…
-
 New
NewDigital Sight Cameras for Micr…
-

Shedding New Light On Microsco…
-

Nikon ECLIPSE LV100ND POL/DS P…
-

Nikon ECLIPSE LV100N POL Polar…
-

Smart Station SS-250
-

Nikon ECLIPSE Ci POL Polarized…
-

Nikon ECLIPSE E200 POL Educati…
-

Nikon ECLIPSE Ti2 Inverted Res…
-

Nikon ECLIPSE Ts2R Inverted Re…
-

Nikon ECLIPSE Ts2 Inverted Rou…
-

Nikon ECLIPSE Ni Upright Micro…
-

Nikon ECLIPSE Ci Upright Micro…
-
 New
NewNikon ECLIPSE Si Upright Micro…
-

TissueScope™ LE
-

IVOS II : Computer Asissted Sp…
-
 New
NewNikon Eclipse Ei educational m…
-

sidtest1
-

Water Jacket Penguin AQ AP ser…
-

TissueScope™ LE120
-

Holotomography Microscope
-

Stereo Microscope (Paralell) S…
-

Panoptiq 3
-

Cell Cut
-

Cellector
-
Xvivo 3